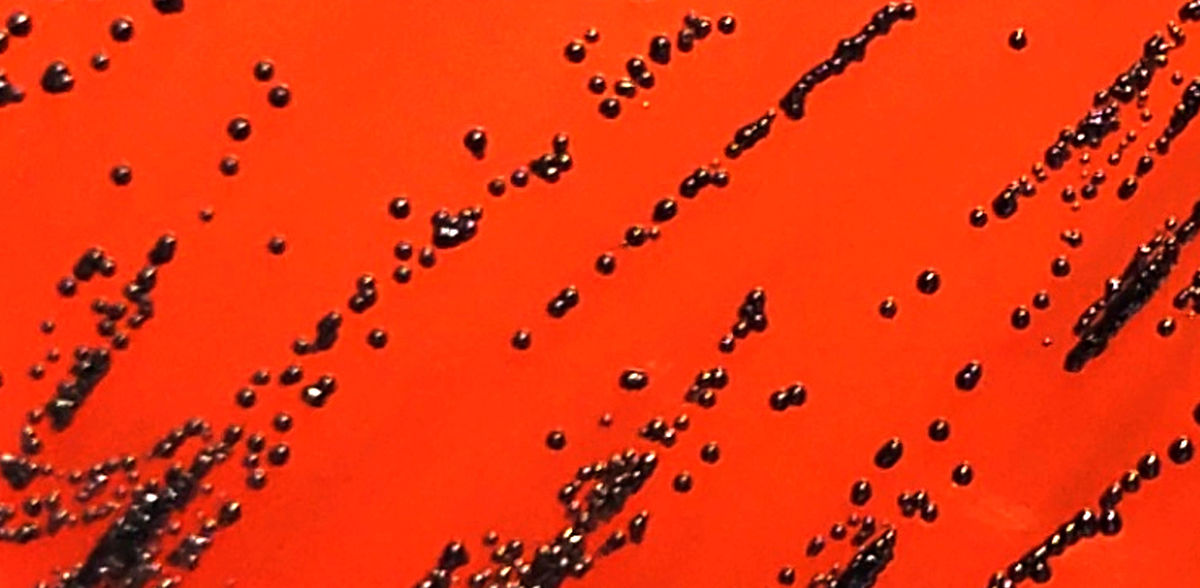

La plus grande épidémie de diphtérie en Europe occidentale depuis 70 ans
L'étude retrace les voies de transmission
Annonces
En 2022, l'Europe occidentale a connu la plus forte augmentation du nombre de cas de diphtérie signalés depuis 70 ans. Les données cliniques et génomiques de l'épidémie indiquent des voies de transmission le long des voies de migration établies vers l'Europe. Des interventions rapides ont permis d'endiguer l'épidémie, mais les souches de cette période continuent de provoquer de nouvelles infections dans la région.
Tout au long de l'année 2022, plusieurs pays européens ont signalé un nombre anormalement élevé d'infections causées par Corynebacterium diphtheriae, touchant principalement des réfugiés récemment arrivés. À l'époque, la transmission au sein des populations locales des pays touchés n'était pas documentée.
Une nouvelle étude publiée dans le New England Journal of Medicine (NEJM) révèle maintenant, pour la première fois, les voies de transmission impliquées. Un consortium de recherche européen a analysé les profils génomiques de 363 isolats bactériens. Ces échantillons provenaient de patients de 10 pays ayant signalé une augmentation des cas de diphtérie entre janvier et fin novembre 2022, et qui ont analysé conjointement leurs données de séquençage : Allemagne (118 isolats), Autriche (66), Royaume-Uni (59), Suisse (52), France (30), Belgique (21), Norvège (8), Pays-Bas (5), Italie (3) et Espagne (1).
Transmission de la diphtérie le long des itinéraires des migrants
"Les souches de diphtérie signalées en 2022 présentent un degré élevé de similitude génétique, ce qui indique soit une source commune d'infection, soit des lieux spécifiques le long des routes migratoires vers l'Europe où une transmission soutenue s'est produite", explique Andreas Hoefer, expert en microbiologie au Centre européen de prévention et de contrôle des maladies (CEPCM) et coauteur de l'étude.
Selon l'étude, la quasi-totalité des 362 patients (98 %) étaient des hommes, âgés en moyenne de 18 ans au moment de la collecte des données. La majorité d'entre eux (96 %) avaient récemment quitté leur pays d'origine pour se rendre dans les pays où la diphtérie a été diagnostiquée par la suite. Sur les 266 patients pour lesquels des données sur le pays d'origine étaient disponibles, 222 (83 %) étaient originaires d'Afghanistan ou de Syrie. La plupart d'entre eux ont suivi des itinéraires migratoires passant par les pays des Balkans occidentaux jusqu'à leur destination, avec un total de 28 pays de transit documentés.
Sur les 346 patients pour lesquels des données cliniques étaient disponibles, 268 (77 %) avaient une diphtérie cutanée, qui affecte la peau, tandis que 52 (15 %) avaient une forme respiratoire qui attaque les voies respiratoires. "La diphtérie se manifeste par un large éventail de symptômes cliniques. Les complications respiratoires causées par les bactéries productrices de toxines, qui peuvent être mortelles, sont particulièrement redoutées", explique Adrian Egli, directeur de l'Institut de microbiologie médicale de l'université de Zurich et l'un des responsables de l'étude.
L'échange rapide des données de séquençage a permis une réaction rapide dans toute l'Europe
"Le partage rapide des données de séquençage génomique entre les pays déclarants a permis de définir les points communs des souches de diphtérie au-delà des frontières", ajoute Sylvain Brisse, professeur à l'Institut Pasteur et autre auteur principal de l'étude.
"La détection du premier cas de diphtérie respiratoire en Autriche depuis près de 30 ans, en 2022, souligne l'importance cruciale du partage d'informations transfrontalières et de la collaboration internationale dans la lutte contre les épidémies", déclare Stefanie Schindler, microbiologiste à l'Agence autrichienne pour la santé et la sécurité alimentaire (AGES) et coauteur de l'étude. "Nous avons remarqué une augmentation spectaculaire du nombre de bactéries diphtériques productrices de toxines en Allemagne au cours de l'été 2022, et nous avons d'abord informé nos collègues autrichiens et suisses du réseau européen informel sur la diphtérie", explique Andreas Sing, responsable du laboratoire national de référence pour la diphtérie en Allemagne au sein de l'autorité bavaroise de la santé et de la sécurité alimentaire (LGL).
L'analyse du séquençage a également permis de mieux comprendre la sensibilité aux antibiotiques des souches bactériennes, confirmée par la suite par des tests de sensibilité aux antimicrobiens. Ces informations ont permis d'orienter les mesures de santé publique, notamment l'identification et le dépistage de la résistance à des antibiotiques tels que l'érythromycine.
Mettre à jour les vaccinations et rester vigilant
Il a été difficile d'évaluer le statut vaccinal des patients touchés en raison d'une documentation médicale incomplète. Selon les données disponibles, seuls quatre patients avaient été vaccinés contre la diphtérie, dix ont déclaré ne pas avoir été vaccinés et le statut vaccinal de 290 patients n'était pas connu. Pour ceux qui ont terminé leur série de vaccinations contre la diphtérie, la probabilité de contracter la maladie est très faible. En général, une vaccination de rappel 10 ans après la dernière dose suffit pour maintenir la protection.
Silvia Funke, experte du CEPCM sur les maladies évitables par la vaccination, conclut que "l'étude montre combien il est important de s'assurer que le statut vaccinal de chacun contre la diphtérie est à jour, y compris parmi les personnes vulnérables telles que les migrants, les sans-abri, les personnes qui s'injectent des drogues ou les personnes non vaccinées. Cela signifie également que les cliniciens doivent être vigilants et prêter attention aux symptômes de la diphtérie, en particulier lorsque leurs patients appartiennent à des groupes vulnérables ou ont un lien quelconque avec ces populations".
À la fin de l'année 2022, des interventions rapides telles que la recherche des contacts et le dépistage des cas secondaires ont permis d'endiguer l'épidémie de manière significative. Toutefois, les données génomiques montrent que certaines souches continuent de circuler, ce qui incite les autorités de santé publique et les prestataires de soins de santé à rester vigilants. "À ce jour, ni l'étendue de la circulation, ni le lieu exact de l'infection n'ont été déterminés. C'est pourquoi les professionnels de la santé publique et les prestataires de soins doivent rester vigilants afin d'éviter une nouvelle propagation de la diphtérie en Europe", souligne M. Hoefer.
Note: Cet article a été traduit à l'aide d'un système informatique sans intervention humaine. LUMITOS propose ces traductions automatiques pour présenter un plus large éventail d'actualités. Comme cet article a été traduit avec traduction automatique, il est possible qu'il contienne des erreurs de vocabulaire, de syntaxe ou de grammaire. L'article original dans Anglais peut être trouvé ici.